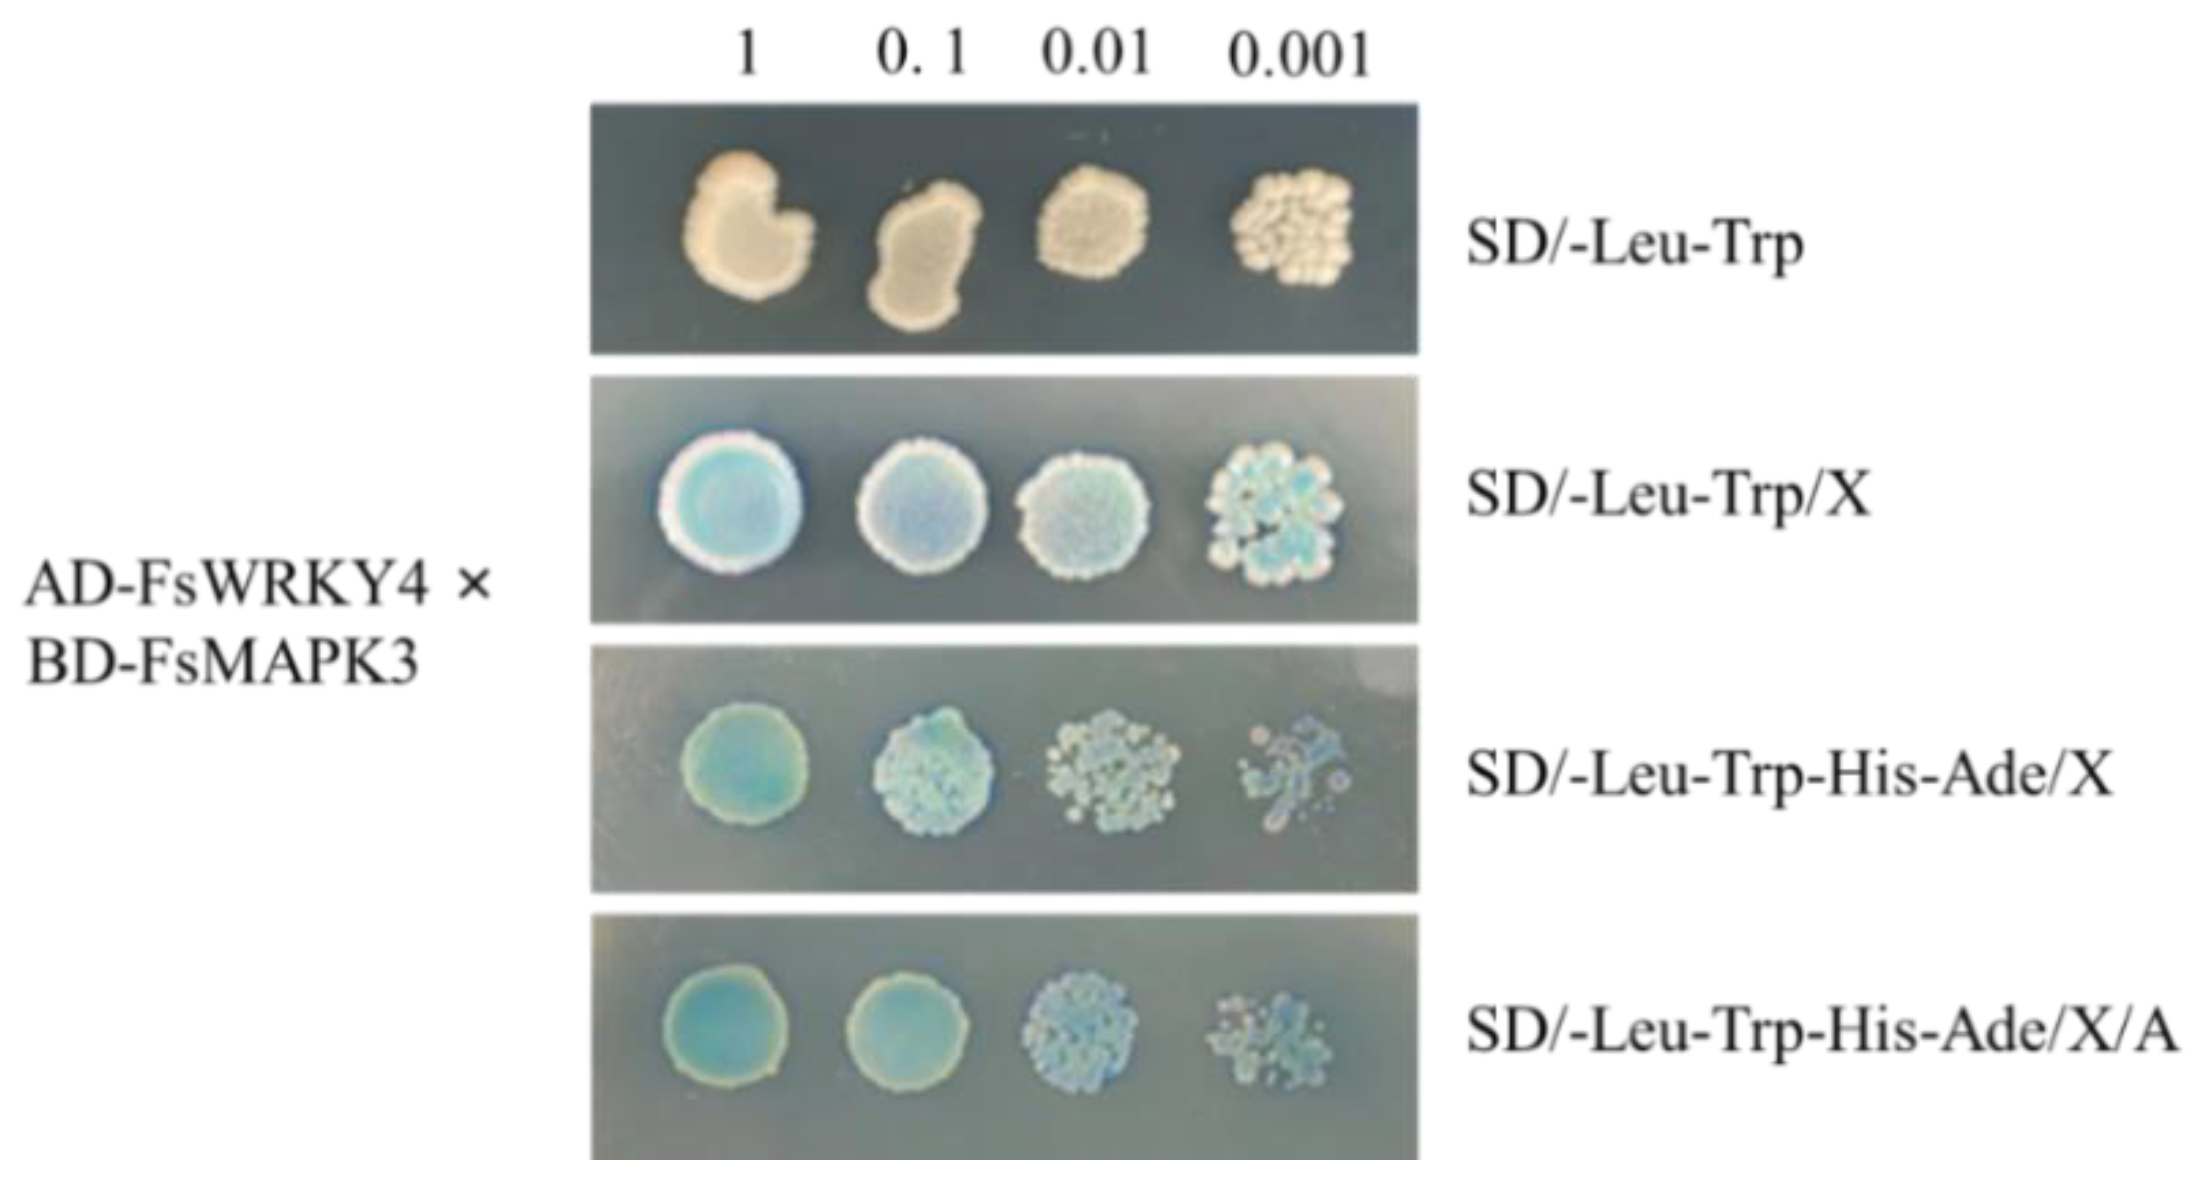

Gene Expression and Interaction Analysis of FsWRKY4 and FsMAPK3 in Forsythia suspensa
Abstract
:1. Introduction
2. Results
2.1. Cloning of FsWRKY4 and FsMAPK3
2.2. Spatiotemporal Expression Patterns of FsWRKY4 and FsMAPK3
2.3. Subcellular Localization Analysis of FsWRKY4 and FsMAPK3 Proteins
2.4. Yeast Toxicity Testing
2.5. Yeast Two-Hybrid Recombinant Plasmid Self-Activation Assay
2.6. Analysis of FsWRKY4 and FsMAPK3 Protein Interactions
3. Discussion
4. Materials and Methods
4.1. Acquisition of Test Materials
4.2. RNA Isolation
4.3. Cloning of FsWRKY4 and FsMAPK3 Genes in F. suspensa
4.4. Quantitative Real-Time Polymerase Chain Reaction Analysis
4.5. Subcellular Localization of FsWRKY4 and FsMAPK3
4.6. Yeast Two-Hybrid
4.7. Statistic Analysis
5. Conclusions
Author Contributions
Funding
Institutional Review Board Statement
Informed Consent Statement
Data Availability Statement
Acknowledgments
Conflicts of Interest
References
- Chen, H.; Ren, Z.; Huang, B.; Li, X.; Ren, S. Study on the Photosynthetic Characteristics of Forsythia suspensa in Different Regions. For. Ecol. Sci. 2023, 38, 218–226. [Google Scholar]
- Bao, J.; Cheng-Wei, H. Forsythiae fructus inhibits melanoma growth through activating MAPKs/Nrf2/HO-1 signaling and modulating glycerophospholipid metabolism. Chin. J. Pharmacol. Toxicol. 2021, 35, 728. [Google Scholar]
- Qi, L.; Chen, H.; Jin, H.; Li, J.; He, J.; Chang, Y. Advances in chemical composition and pharmacological activity of the Chinese herb forsythia. J. Tianjin Univ. Tradit. Chin. Med. 2021, 40, 168–175. [Google Scholar]
- Zhang, W. Analysis on the development model of forsythia. Hebei Agric. 2022, 6, 28–29. [Google Scholar]
- Kriegshauser, L.; Knosp, S.; Grienenberger, E.; Tatsumi, K.; Gütle, D.; Sørensen, I.; Herrgott, L.; Zumsteg, J.; Rose, J.; Reski, R.; et al. Function of the Hydroxycinnamoyl-CoA:Shikimate Hydroxycinnamoyl Transferase is evolutionarily conserved in embryophytes. Plant Cell 2021, 33, 1472–1491. [Google Scholar] [CrossRef]
- Dong, N.; Lin, H. Contribution of phenylpropanoid metabolism to plant development and plant-environment interactions. J. Integr. Plant. Biol. 2021, 63, 180–209. [Google Scholar] [CrossRef]
- Barros, J.; Dixon, R.D. Plant Phenylalanine/Tyrosine Ammonia-lyases. Trends Plant. Sci. 2020, 25, 66–79. [Google Scholar] [CrossRef]
- Shang, J.; Wu, W.; Ma, Y. Metabolic pathways of benzyl propane in plants. Chin. J. Biochem. Mol. Biol. 2022, 38, 1467–1476. [Google Scholar]
- Yang, L.; Yang, C.; Li, C.; Zhao, Q.; Liu, L.; Fang, X.; Chen, X. Recent advances in biosynthesis of bioactive compounds in traditional Chinese medicinal plants. Sci. Bull. 2016, 61, 3–17. [Google Scholar] [CrossRef]
- Jing, F.; Li, F.; Zhang, T.; Lu, X.; Zhao, T.; Feng, S. Recent research progress on chemical composition and biological activity of forsythia. Chin. Mater. Medica 2023, 1, 243–252. [Google Scholar]
- Pharmacopoeia Committee of the People’s Republic of China. Pharmacopoeia of the People’s Republic of China: Part I; China Pharmaceutical Science and Technology Press: Beijing, China, 2020. [Google Scholar]
- Wang, Z.; Xia, Q.; Liu, X.; Liu, W.; Huang, W.; Mei, X.; Luo, J.; Shan, M.; Lin, R.; Zou, D.; et al. Phytochemistry, pharmacology, quality control and future research of Forsythia suspensa (Thunb.) Vahl: A review. J. Ethnopharmacol. 2018, 210, 318–339. [Google Scholar] [CrossRef]
- Xu, Q.; Dai, H.; Duanmu, Y.; Li, M.; Peng, D.; Wang, F.; Li, R.; Ding, Y.; Fang, L. Current status of research on Chinese medicine against novel coronavirus. Jiangxi Tradit. Chin. Med. 2023, 54, 71–75. [Google Scholar] [CrossRef]
- Zhong, W.; Chai, Y.; Zhang, K.; Chen, X.; Lv, K.; Tao, L. Study on the Cytochrome P450s in Phenylpropanoid Metabolic Pathway. J. Anhui Agric. Sci. 2008, 13, 5285–5289. [Google Scholar]
- Rahman, M.; Dewick, P.; Jackson, D.; Lucas, J. Biosynthesis of lignans in Forsythia intermedia. Phytochemistry 1990, 29, 1841–1846. [Google Scholar] [CrossRef]
- Ishiguro, S.; Nakamura, K. Characterization of a cDNA encoding a novel DNA-binding protein, SPF1, that recognizes SP8 sequences in the 5′ upstream regions of genes coding for sporamin and β-amylase from sweet potato. Mol. Gen. Genet. 1994, 244, 563–571. [Google Scholar] [CrossRef] [PubMed]
- Di, P.; Wang, P.; Yan, M.; Han, P.; Huang, X.; Yin, L.; Yan, Y.; Xu, Y.; Wang, Y. Genome-wide characterization and analysis of WRKY transcription factors in Panax ginseng. BMC Genom. 2021, 22, 834. [Google Scholar] [CrossRef]
- Paolis, A.; Caretto, S.; Quarta, A.; Sansebastiano, G.; Sbrocca, I.; Mita, G.; Frugis, G. Genome-Wide Identification of WRKY Genes in Artemisia annua: Characterization of a Putative Ortholog of AtWRKY40. Plants 2020, 9, 1669. [Google Scholar] [CrossRef]
- Zhang, R.; Chen, Z.; Zhang, L.; Yao, W.; Xu, Z.; Liao, B.; Mi, Y.; Gao, H.; Jiang, C.; Duan, L.; et al. Genomic Characterization of WRKY Transcription Factors Related to Andrographolide Biosynthesis in Andrographis paniculata. Front. Genet. 2021, 11, 601689. [Google Scholar] [CrossRef] [PubMed]
- Li, J.; Xiong, Y.; Li, Y.; Ye, S.; Yin, Q.; Gao, S.; Yang, D.; Yang, M.; Palva, E.; Deng, X. Comprehensive Analysis and Functional Studies of WRKY Transcription Factors in Nelumbo nucifera. Int. J. Mol. Sci. 2019, 20, 5006. [Google Scholar] [CrossRef] [PubMed]
- Duan, L.; Xie, L.; Ma, Y.; He, J. The regulatory role of transcription factors on secondary metabolism in medicinal plants. J. Chin. Med. Mater. 2021, 44, 1002–1007. [Google Scholar]
- Tang, J.; Qi, L.; He, X.; Jiang, Y.; Li, Z. Cloning of ZoWRKY1 gene in ginger and its correlation with 6-gingerol biosynthesis. Hunan Agric. Sci. 2020, 10, 1–5. [Google Scholar]
- Guillaumie, S.; Mzid, R.; Méchin, V.; Léon, C.; Hichri, I.; Destrac-Irvine, A.; Trossat-Magnin, C.; Delrot, S.; Lauvergeat, V. The grapevine transcription factor WRKY2 influences the lignin pathway and xylem development in tobacco. Plant Mol. Biol. 2010, 72, 215–234. [Google Scholar] [CrossRef] [PubMed]
- Jiang, R. Functional Studies on the Regulation of Artemisinin Biosynthesis by AaMAPK4; Southwest University: Chongqing, China, 2021; p. 11. [Google Scholar]
- Gai, Q.; Jiao, J.; Wang, X.; Liu, J.; Wang, Z.; Fu, Y. Chitosan promoting formononetin and calycosin accumulation in Astragalus membranaceus hairy root cultures via mitogen-activated protein kinase signaling cascades. Sci. Rep. 2019, 9, 10367. [Google Scholar] [CrossRef] [PubMed]
- LI, S.; Wang, W.; Gao, J.; Yin, K.; Wang, R.; Wang, C.; Petersen, M.; Mundy, J.; Qiu, J. MYB75 Phosphorylation by MPK4 Is Required for Light-Induced Anthocyanin Accumulation in Arabidopsis. Plant Cell 2016, 28, 2866–2883. [Google Scholar] [CrossRef] [PubMed]
- Xie, Y.; Ding, M.; Zhang, B.; Yang, J.; Pei, T.; Ma, P.; Dong, J. Genome-wide characterization and expression profiling of MAPK cascade genes in Salvia miltiorrhiza reveals the function of SmMAPK3 and SmMAPK1 in secondary metabolism. BMC Genom. 2020, 21, 630. [Google Scholar] [CrossRef] [PubMed]
- Chen, S.; Weng, Q.; Cao, H.; Sun, X. Progress of research on the functions and regulatory mechanisms of WRKY transcription factors in biotic and abiotic stresses. J. Agric. Biotechnol. 2017, 25, 668–682. [Google Scholar]
- Li, F.; Li, M.; Wang, P.; Jr, K.; Duan, L.; Dever, J.; Shan, L.; Li, Z.; He, P. Regulation of cotton (Gossypium hirsutum) drought responses by mitogen-activated protein (MAP) kinase cascade-mediated phosphorylation of Gh WRKY 59. New Phytol. 2017, 215, 1462–1475. [Google Scholar] [CrossRef]
- Menke, F.; Kang, H.; Chen, Z.; Park, J.; Kumar, D.; Klessig, D. Tobacco transcription factor WRKY1 is phosphorylated by the MAP kinase SIPK and mediates HR-like cell death in tobacco. Mol. Plant Microbe Interact. 2005, 18, 1027–1034. [Google Scholar] [CrossRef]
- Zhang, J.; Liu, X.; Chen, J.; Guo, G.; Tan, X.; Zhao, X.; Xu, H.; Liu, H.; Hou, D. Screening and identification of transcription factors WRKY involved in phenylpropane synthesis pathway in Forsythia suspensa. Chin. Tradit. Herb. Drugs 2023, 18, 6055–6064. [Google Scholar]
- Kang, M.; Zhang, W.; Zhao, L.; Bao, H. Reconstructing this herb—Forsythia suspensa. Jilin Chin. Med. 2023, 43, 331–334. [Google Scholar]
- Wang, T.; Zhang, H.; Yang, Z.; Zhao, S.; Li, Y.; Song, W.; Pu, J.; Zhang, L. Study on the antibacterial and anti-inflammatory activities of forsythia and forsythia leaves and their main chemical components. China Drugs Clin. 2019, 19, 2380–2381. [Google Scholar]
- Wei, H. Henan’s native medicinal herbs forsythia. Henan Agric. 2023, 639, 2. [Google Scholar]
- Li, X.; Yang, J.; Xue, Z. Characteristics of forsythia and advantages of its development in Nanyang City. Mod. Agric. Sci. Technol. 2022, 24, 73–76. [Google Scholar]
- Li, P.; Li, X.; Jiang, M. CRISPR/Cas9-mediated mutagenesis of WRKY3 and WRKY4 function decreases salt and Me-JA stress tolerance in Arabidopsis thaliana. Mol. Biol. Rep. 2021, 8, 5821–5832. [Google Scholar] [CrossRef] [PubMed]
- Nakkeeran, S.; Rajamanickam, S.; Saravanan, R.; Vanthana, M.; Soorianathasundaram, K. Bacterial endophytome-mediated resistance in banana for the management of Fusarium wilt. 3 Biotech. 2021, 6, 267. [Google Scholar] [CrossRef]
- Soliman, S.; Hafez, E.; Al-Kolaibe, A.; Razik, E.; Abd-Ellatif, S.; Ibrahim, A.; Kabeil, S.; Elshafie, H. Biochemical Characterization, Antifungal Activity, and Relative Gene Expression of Two Mentha Essential Oils Controlling Fusarium oxysporum, the Causal Agent of Lycopersicon esculentum Root Rot. Plants Basel 2022, 2, 189. [Google Scholar] [CrossRef]
- Sun, T.; Wang, C.; Liu, R.; Zhang, Y.; Wang, Y.; Wang, L. ThHSFA1 Confers Salt Stress Tolerance through Modulation of Reactive Oxygen Species Scavenging by Directly Regulating ThWRKY4. Int. J. Mol. Sci. 2021, 9, 5048. [Google Scholar] [CrossRef]
- Fabiola, M.; Mao, X.; Clint, C. Linking phenylpropanoid metabolism, lignin deposition and plant growth inhibition. Curr. Opin. Biotech. 2019, 56C, 202–208. [Google Scholar]
- Tena, G.; Asai, T.; Chiu, W.; Sheen, J. Plant mitogen-activated protein kinase signaling cascades. Curr. Opin. Plant Biol. 2001, 4, 392–400. [Google Scholar] [CrossRef]
- Wang, S.; Xie, X.; Che, X.; Lai, W.; Ren, Y.; Fan, X.; Hu, W.; Tang, M.; Chen, H. Host- and virus-induced gene silencing of HOG1-MAPK cascade genes in Rhizophagus irregularis inhibit arbuscule development and reduce resistance of plants to drought stress. Plant Biotechnol. J. 2023, 21, 866–883. [Google Scholar] [CrossRef]
- Samuel, M.; Miles, G.; Ellis, B. Ozone treatment rapidly activates MAP kinase signalling in plants. Plant J. 2000, 22, 367–376. [Google Scholar] [CrossRef]
- Liu, Q.; Xu, L.; Li, Y.; Xu, W.; Vetukuri, R.; Xu, X. Overexpression of an autophagy-related gene DiATG3 from Davidia involucrata improves plant thermotolerance by enhancing the accumulation of polyamines and regulating genes in calcium and MAPK signaling pathways. Environ. Exp. Bot. 2023, 208, 105235. [Google Scholar] [CrossRef]
- Jonak, C.; Hirt, N. Heavy Metal Stress. Activation of Distinct Mitogen-Activated Protein Kinase Pathways by Copper and Cadmium. Plant Physiol. 2004, 136, 3276–3283. [Google Scholar] [CrossRef]
- Tapan, B.; Tarapati, R.; Ghallab, H.; Alotaibi, S.; Maaz, N.; Aayush, S.; Sukhbir, S.; Neelam, S.; Yosif, A.; Ahmed, A.; et al. Polyphenols inhibiting MAPK signalling pathway mediated oxidative stress and inflammation in depression. Biomed. Pharmacother. 2022, 146, 112545. [Google Scholar]
- Majeed, Y.; Zhu, X.; Zhang, N.; Raza, A.; Haider, F.U.; Si, H. Harnessing the role of mitogen-activated protein kinases against abiotic stresses in plants. Front. Plant Sci. 2023, 14, 932923. [Google Scholar] [CrossRef] [PubMed]
- Wang, L.; Guo, D.; Zhao, G.; Wang, J.; Zhang, S.; Wang, C.; Guo, X. Group IIc WRKY transcription factors regulate cotton resistance to Fusarium oxysporum by promoting GhMKK2-mediated flavonoid biosynthesis. New Phytol. 2022, 236, 249–265. [Google Scholar] [CrossRef] [PubMed]
- Kishi-Kaboshi, M.; Takahashi, A.; Hirochika, H. MAMP-responsive MAPK cascades regulate phytoalexin biosynthesis. Plant Signal. Behav. 2010, 5, 1653–1656. [Google Scholar] [CrossRef]
- Wang, Y.; Schuck, S.; Wu, J.; Yang, P.; Döring, A.C.; Zeier, J.; Tsuda, K. A MPK3/6-WRKY33-ALD1-pipecolic acid regulatory loop contributes to systemic acquired resistance. Plant Cell 2018, 30, 2480–2494. [Google Scholar] [CrossRef]
- Pascal, P.; Lennart, E.; Siska, H.; Katja, K.; Kai, N.; Gerit, B.; Joachim, U.; Martin, W.; Dierk, S.; Justin, L. The Arabidopsis thaliana mitogen-activated protein kinases MPK3 and MPK6 target a subclass of ‘VQ-motif’-containing proteins to regulate immune responses. New Phytol. 2014, 2, 592–606. [Google Scholar]
- Yao, D.; Zou, C.; Shu, Y.; Liu, S. WRKY Transcription Factors in Nicotiana tabacum Modulate Plant Immunity against Whitefly via Interacting with MAPK Cascade Pathways. Insects 2020, 1, 16. [Google Scholar] [CrossRef]
- Chen, X.; Yang, X.; Xie, J.; Ding, W.; Li, Y.; Yue, Y.; Wang, L. Biochemical and Comparative Transcriptome Analyses Reveal Key Genes Involved in Major Metabolic Regulation Related to Colored Leaf Formation in Osmanthus fragrans ‘Yinbi Shuanghui’ during Development. Biomolecules 2020, 4, 549. [Google Scholar] [CrossRef] [PubMed]
- Xie, Y.; Ding, M.; Yin, X.; Wang, G.; Zhang, B.; Chen, L.; Ma, P.; Dong, J. MAPKK2/4/5/7-MAPK3-JAZs modulate phenolic acid biosynthesis in Salvia miltiorrhiza. Phytochemistry 2022, 199, 113177. [Google Scholar] [CrossRef] [PubMed]

| Target Gene | Primer Name | Primer Sequence (5′-3′) |
|---|---|---|
| FsWRKY4 | FsWRKY4-F | AATTCACATTCATGGCCACTAC |
| FsWRKY4-R | CAAAACAGAAAGCTCGCTCTCT | |
| FsMAPK3 | FsMAPK3-F | TTGTCCGAATAGACAGTTGAAGC |
| FsMAPK3-R | TAAGATGGCAGAGAAGAGTGGTG |
| Target Gene | Primer Name | Primer Sequence (5′-3′) |
|---|---|---|
| FsWRKY4 | qFsWRKY4-F | GCGGTGGAGAATAAGGAGGA |
| qFsWRKY4-R | CGGAACAAACCCAGGAGAAT | |
| FsMAPK3 | qFsMAPK3-F | GACGTGTGGTCTGTAGGTTGC |
| qFsMAPK3-R | TTCTCTTTCCGGGATTGATTG | |
| FsUKN1 | qFsUKN1-F | CAGACCAGCTTTGAGGAGTATC |
| qFsUKN1-R | GGCCAGAAACCAGTAGTCAATA |
| Target Gene | Primer Name | Primer Sequence (5′-3′) |
|---|---|---|
| FsWRKY4 | GFP-FsWRKY4-F | gcccttgctcaccatGTCGACATGGCTGAGAACCAACCTCCT |
| GFP-FsWRKY4-R | cgggggactgagctcGGTACCAGAAAGTTGTGTTACCTGTTCTTCTTTG | |
| FsMAPK3 | GFP-FsMAPK3-F | cgggggactgagctcGGTACCATGACAGAGTATGTTGTCACCAGATG |
| GFP-FsMAPK3-R | gcccttgctcaccatGTCGACGATATTTAGTGCCAAAGCCTCCTG |
| Target Gene | Primer Name | Primer Sequence (5′-3′) |
|---|---|---|
| FsWRKY4 | AD-FsWRKY4-F | gtaccagattacgctCATATGATGGCTGAGAACCAACCTCCT |
| AD-FsWRKY4-R | cagctcgagctcgatGGATCCTCAAGAAAGTTGTGTTACCTGTTCTTC | |
| FsMAPK3 | BD-FsMAPK3-F | tcagaggaggacctgCATATGATGACAGAGTATGTTGTCACCAGATG |
| BD-FsMAPK3-R | ccgctgcaggtcgacGGATCCTTAGATATTTAGTGCCAAAGCCTCC |
Disclaimer/Publisher’s Note: The statements, opinions and data contained in all publications are solely those of the individual author(s) and contributor(s) and not of MDPI and/or the editor(s). MDPI and/or the editor(s) disclaim responsibility for any injury to people or property resulting from any ideas, methods, instructions or products referred to in the content. |
© 2023 by the authors. Licensee MDPI, Basel, Switzerland. This article is an open access article distributed under the terms and conditions of the Creative Commons Attribution (CC BY) license (https://creativecommons.org/licenses/by/4.0/).
Share and Cite
Tan, X.; Chen, J.; Zhang, J.; Guo, G.; Zhang, H.; Zhao, X.; Lv, S.; Xu, H.; Hou, D. Gene Expression and Interaction Analysis of FsWRKY4 and FsMAPK3 in Forsythia suspensa. Plants 2023, 12, 3415. https://doi.org/10.3390/plants12193415
Tan X, Chen J, Zhang J, Guo G, Zhang H, Zhao X, Lv S, Xu H, Hou D. Gene Expression and Interaction Analysis of FsWRKY4 and FsMAPK3 in Forsythia suspensa. Plants. 2023; 12(19):3415. https://doi.org/10.3390/plants12193415
Chicago/Turabian StyleTan, Xinjie, Jiaxi Chen, Jiaqi Zhang, Guangyang Guo, Hongxiao Zhang, Xingli Zhao, Shufang Lv, Huawei Xu, and Dianyun Hou. 2023. "Gene Expression and Interaction Analysis of FsWRKY4 and FsMAPK3 in Forsythia suspensa" Plants 12, no. 19: 3415. https://doi.org/10.3390/plants12193415
APA StyleTan, X., Chen, J., Zhang, J., Guo, G., Zhang, H., Zhao, X., Lv, S., Xu, H., & Hou, D. (2023). Gene Expression and Interaction Analysis of FsWRKY4 and FsMAPK3 in Forsythia suspensa. Plants, 12(19), 3415. https://doi.org/10.3390/plants12193415

